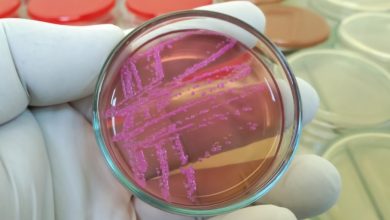

Antibióticos
-
BeKids

Antibióticos en la infancia elevan el riesgo de obesidad
Un estudio realizado en Finlandia evidenció que los niños que fueron expuestos a antibióticos durante los primeros dos años de…
-
*Apoyado por Asma

¿Cómo se relaciona el asma infantil con el uso de antibióticos?
El asma infantil no es una enfermedad diferente al asma en adultos, pero los niños enfrentan retos especiales por su…
-
BeKids

Apendicitis infantil: Estudio resuelve el debate entre la cirugía y los antibióticos
La apendicitis es una afección dolorosa en la que el apéndice se inflama y se llena de pus. Generalmente, comienza…
-
BeHealth News

FDA aprobó tratamiento para infecciones intraabdominales complicadas
La resistencia bacteriana es uno de los mayores desafíos de la medicina moderna. Cada año, millones de personas en el…
-
BeHealth News

Resistencia antimicrobiana, la próxima gran emergencia sanitaria mundial
Un reciente estudio publicado por un equipo internacional de investigadores en la revista The Lancet advierte que la resistencia a…
-
Be LATAM

Doctora resalta importancia de no mezclar antibióticos y alcohol
De igual modo, ante cualquier duda, falta de información o reacción no esperada asociada al tratamiento, consultar al médico o…
-
BeKids

Efecto de los antibióticos en las enfermedades infantiles comunes
Los antibióticos son medicamentos que combaten infecciones causadas por bacterias.
-
*Apoyado por Crohns & Colitis

¿El uso de antibióticos está relacionado con la enfermedad de Crohn y la colitis ulcerosa?
La Revista Gut ha publicado un estudio que revela que las personas mayores de 40 años deben ser cautelosas en…
-
Bienestar General

Alerta por infección estomacal que no responde a antibióticos
El esquema de salud pública encendió sus alarmas debido al aumento de contagios de Shigella, un tipo de bacteria que…
-
*Apoyado por Colitis Ulcerosa

¿Cómo elegir el tratamiento correcto tras un diagnóstico de EII?
El Dr. Víctor L. Carlo, catedrático asociado y director de gastroenterología del RCM, destacó las opciones de tratamiento médico más…